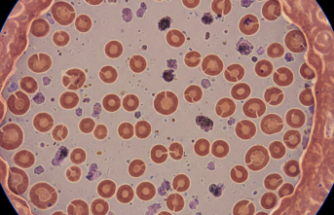
Kanın Rengi Solarken: Talasemi ile Yaşam Mücadelesi

Agresif Bir Düşman: Burkitt Lenfoma ile Tanışma
Hızlıyız. Tıp dünyası bugünlerde çocukluk çağı kanserlerinde en çevik davranan türlerden birini konuşuyor. Burkitt lenfoma dediğimiz bu tablo, aslında bağışıklık sisteminin koruyucu neferleri olan B-hücrelerinin kontrolden çıkmasıyla başlıyor. Geçtiğimiz Ekim ayının başlarında yapılan bir panelde uzmanlar, bu tümörün vücuttaki en hızlı bölünen hücre yapısına sahip olduğunun altını çizdi.
Hastalık genelde çene kemiğinde veya karın bölgesinde şişliklerle kendini belli ediyor. Tanı süreci bazen çok kafa karıştırıcı olabilir. Acaba basit bir enfeksiyon mu yoksa daha ciddi bir durum mu var diye düşünürken zaman akıp gidiyor. Tetkiklerde "yıldızlı gökyüzü" manzarası (hücrelerin mikroskoptaki özel görüntüsü) görüldüğünde doktorlar hemen harekete geçiyor. Sarsıyor bazen bu durum insanı ama vakit kaybetmemek hayati önem taşıyor.
Tedavide Kritik Günler
Hastane koridorlarında bekleyen ailelerin yüzündeki o hafif kaygı, modern tıbbın gücüyle yerini bazen şaşkınlığa bırakıyor. Kemoterapi (ilaçlı tedavi) protokolleri bu agresif tümörü durdurmak için oldukça sert uygulanıyor. Verilere göre hastaların %82'si ya da %86 gibi bir kısmı ilk yoğun tedaviye olumlu yanıt veriyor. Rakamlar biraz değişken olsa bile sonuçlar umut verici görünüyor. Bahar döneminde yayınlanan raporlar, erken teşhisin başarı şansını ciddi oranda artırdığını gösteriyor.
Bağışıklık sistemini tekrar ayağa kaldırmak için destek tedavileri de sürece ekleniyor. Uzmanlar sıvı alımının ve beslenmenin bu süreçte ne kadar kıymetli olduğunu belirtiyor. Aslında her şey o ilk belirtiyi fark etmekle başlıyor. Karın ağrısı deyip geçmemek, vücuttaki o ani şişliği ciddiye almak gerekiyor.
Geleceğe Dair Güçlü Umutlar
İyileşme oranları her geçen gün daha yüz güldürücü bir seviyeye ulaşıyor. Genetik araştırmalar sayesinde artık kişiye özel tedavi yöntemleri üzerinde duruluyor. Bilim insanları, hücrelerin neden bu kadar hızlı çoğaldığını çözmek üzere yoğun mesai harcamakta. Gelişmeleri medihaber.com’u takip sitemiz ve sosyal medya hesaplarını takip ederek güncel bilgilere ulaşabilirsiniz.
Haber Sözlüğü:
-
B-Lenfosit: Vücudumuzu mikroplara karşı koruyan, antikor üreten beyaz kan hücresi tipi.
-
Metastaz: Kanserli hücrelerin oluştuğu bölgeden başka organlara sıçraması, yayılması durumu.
Etiketler: #burkittlenfoma #sağlıkhaberleri #lenfkanseri #çocuksağlığı #tıptagelişmeler